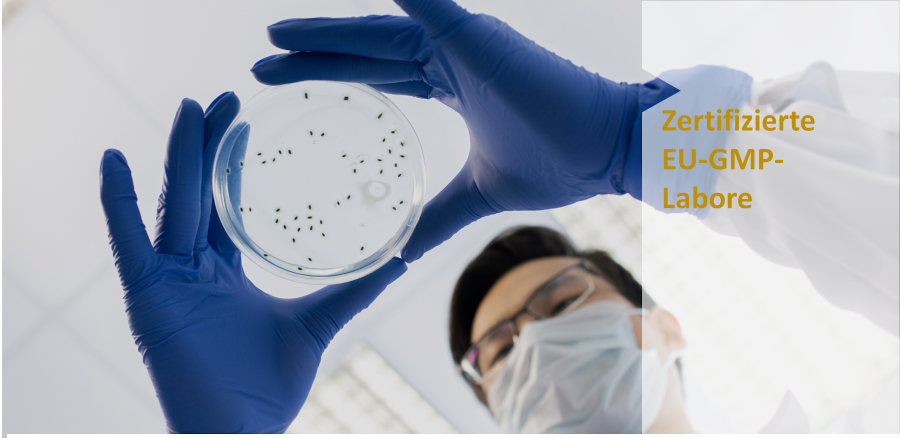

XIAOYAO zertifikate

Tasly verfügt an seiner Produktionsstätte in Tianjin über ein EU-GMP Zertifikat. Die Ware wird in der EU in einem deutschen GLP-Labor erneut getested. Das GXP-Qualitätsmanagement ist ebenfalls in Deutschland ansässig.
EU GMP Zertifikat
.

Das EU-GMP-Zertifikat, auch als EU-Good Manufacturing Practice-Zertifikat bekannt, ist ein wichtiger Bestandteil des Qualitätsmanagementsystems in der pharmazeutischen Industrie innerhalb der Europäischen Union. Dieses Zertifikat dient als Nachweis dafür, dass ein pharmazeutischer Hersteller die GMP-Richtlinien der Europäischen Union in seiner Produktionsstätte eingehalten hat. Unternehmen wie Tasly, die Arzneimittel in der EU herstellen oder in den EU-Markt einführen möchten, müssen sich einem umfassenden Prüfprozess unterziehen, um das EU-GMP-Zertifikat zu erhalten.
Re-Testing in der EU/Deutschland
.

Unser Partner ist ein deutsches unabhängiges, akkreditiertes und behördlich anerkanntes Prüflabor für pflanzliche Arzneimittel, Lebensmittel, Futtermittel und Kosmetika. Der Service umfasst die Analytik, Entwicklung, Qualitätskontrolle und Zulassung pflanzlicher Produkte auf allen Verarbeitungsstufen sowie ein umfangreiches Angebot hochreiner pflanzlicher Referenzsubstanzen. Als Unternehmen im "the nature network" ist die Firma mit ihrem erfahrenen Team und modernstem Equipment der Qualität, Wirksamkeit und Sicherheit pflanzlicher Produkte verpflichtet. Das Labor ist GLP zertifiziert.
Qualitätsmanagement in Deutschland

Qualitätsmanagement spielt in der Pharmaindustrie eine entscheidende Rolle, da die Herstellung von Arzneimitteln höchste Standards und Präzision erfordert, um die Sicherheit und Wirksamkeit der Produkte zu gewährleisten. Die Anwendung eines effektiven Qualitätsmanagementsystems (QMS) ist unerlässlich, um den strengen regulatorischen Anforderungen gerecht zu werden und gleichzeitig die Erwartungen der Patienten zu erfüllen. Unser Partner ist hierfür die deutsche Firma Fortis Pharma.
.

Das EU-GMP-Zertifikat, auch als EU-Good Manufacturing Practice-Zertifikat bekannt, ist ein wichtiger Bestandteil des Qualitätsmanagementsystems in der pharmazeutischen Industrie innerhalb der Europäischen Union. Dieses Zertifikat dient als Nachweis dafür, dass ein pharmazeutischer Hersteller die GMP-Richtlinien der Europäischen Union in seiner Produktionsstätte eingehalten hat. Unternehmen wie Tasly, die Arzneimittel in der EU herstellen oder in den EU-Markt einführen möchten, müssen sich einem umfassenden Prüfprozess unterziehen, um das EU-GMP-Zertifikat zu erhalten.
